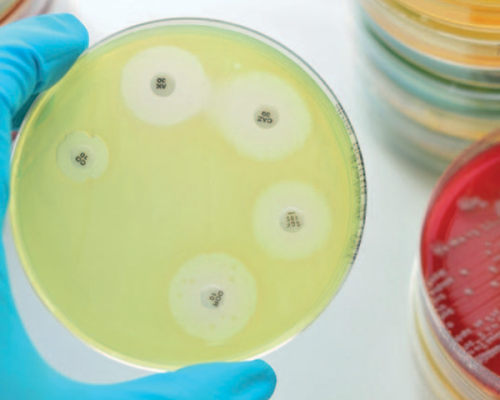

Ante la detección de jabalíes silvestres positivos a peste porcina africana (PPA) en Barcelona, España, el Servicio Nacional de Sanidad...

Ante la detección de jabalíes silvestres positivos a peste porcina africana (PPA) en Barcelona, España, el Servicio Nacional de Sanidad...

La caballa de talla reducida (Scomber colias), capturada como pesca incidental en Mar del Plata, representa un recurso subutilizado con...

La calidad de la carne se puede determinar mediante cuatro parámetros relevantes: nutricional, sensorial, tecnológico y de seguridad.
La serie EcoAMR (Impactos sanitarios y económicos de la resistencia a los antimicrobianos en humanos y animales productores de alimentos),...

El chorizo es uno de los embutidos más representativos y versátiles de la gastronomía mundial, con una presencia consolidada en...

Esta es la primera vez que se notifica una infección por influenza aviar H5 en un cerdo en los Estados...

La fiebre aftosa (FA) es una enfermedad vírica muy contagiosa que afecta a los animales ungulados de pezuña hendida.

El bienestar de los animales es un concepto que debe abordarse en todas las etapas de la vida de los...

El SENASA establece autorizaciones basadas en declaraciones juradas y fiscalización inteligente.

La exportación de productos cárnicos requiere un profundo entendimiento de las regulaciones internacionales. En este artículo, analizamos las normativas más...

El mercado cárnico enfrenta una revolución impulsada por consumidores más conscientes. Este artículo analiza cómo la sostenibilidad, la tecnología y...

Se ha dado el puntapié inicial de la feria líder internacional para los expositores puedan registrarse.